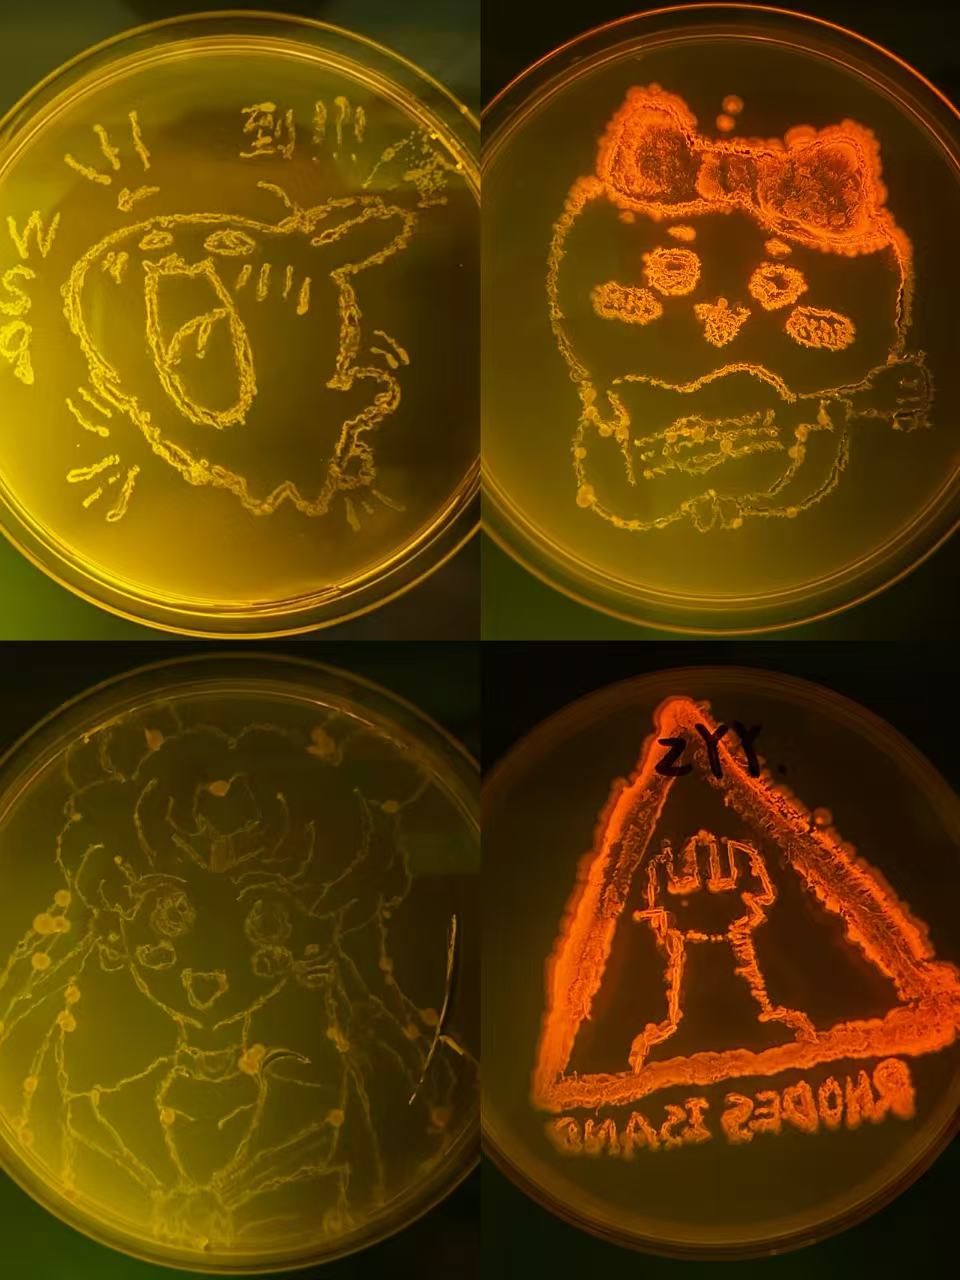

2025年,生物科学实验教学中心以“开放共享、协同创新”为理念,承办了多项社团活动,涵盖植物学、微生物学、生物工程多个生命科学领域,同学们在动手实践中探索科学奥秘,体验创新乐趣。
科学与艺术的奇妙碰撞:微生物细菌作画
“微生物细菌作画”活动生动诠释了科学探究、美育培养与趣味实践的深度融合。活动中,50位跨院系的同学将灭菌培养基作为画布,利用发光细菌进行艺术创作。创作过程既考验艺术构思,又要求同学们严守无菌操作规范、精准控制菌液量以避免晕染,充分体现了科学实验的严谨性。随着培养皿经保温培养后在紫外灯下呈现出灵动的荧光图案,同学们不仅收获了亲手创作的成就感,更深刻领略到了微观世界独有的科学之美与艺术张力。
探索植物微观世界的奥秘:植物组培瓶制作
活动将科学原理与美育实践紧密结合:在理论环节,老师通过实物与图示,重点讲解烟草、杨树等植物的生长特性及无菌操作规范,夯实同学们的科学探究基础;在实操环节,同学们不仅掌握了超净工作台的使用及接种技术,更发挥创意美化组培瓶,实现了严谨科学与个性审美的统一。后续,同学们将组培瓶带回寝室进行长期观察,并在社群交流中记录生命成长的轨迹。此次活动让科学走出课本,让美育融入生活,充分激发了同学们感受生命、探索自然的热情。

图1 工作人员讲解原理实验原理
图2 微生物作画优秀作品

图 3 同学们制作的植物组培瓶
系列活动的圆满落幕,是实验中心开放平台与同学们求知热情的一次完美“双向奔赴”。在这里,枯燥的理论被趣味的实践点亮,严谨的科学被艺术的美学包裹。同学们纷纷表示,这种寓教于乐的模式让他们收获颇丰——不仅巩固了课堂所学,更在动手协作中体会了团队的力量。